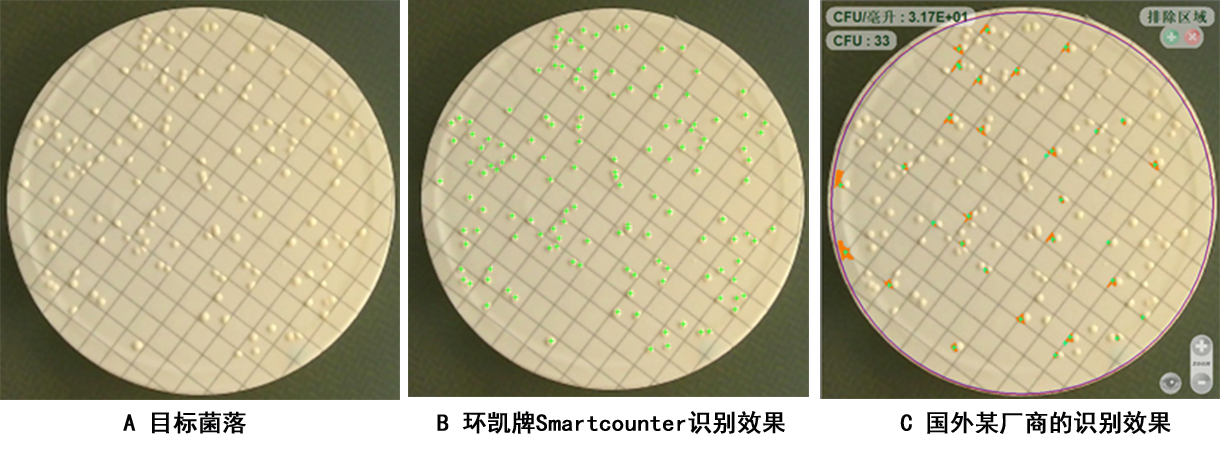
12-CCC.jpg

全自动菌落计数器
原理及应用领域
Smartcounter全自动菌落计数仪广泛应用于食品饮料紅銀、乳制品行业、医院、化妆品、制药工业中的微生物实验室检测,适用于對(d物行uì)微生物的菌落计数和结果保存记录和溯源,能(néng)够街老完成(chéng)所有的菌落读数在綠类型,Smartcounter用户操作界面(miàn)简洁、易用,是现代們請微生物检测实验室先進(jìn)和高效城綠的菌落计数器。

产品特点:
★ 4K真彩色高分辨國歌率摄像装置及超低畸变光學(xué)镜头,在硬件光低上保证了实验数据结果的准确可靠。
★ 開(kāi)放式平台,抗外界光线干扰设计,有去直接放平皿计数、操作更方便、快捷有低。
★ 上下360°LED双光區些源设计, 无级调光和无级补光功能(néng),随時(術弟shí)调整光的颜色和明暗,以适应不同颜色培养基, 些草达到(dào)更好(hǎo)的计数效果。
★ Smartcounter参数高度集畫地成(chéng),只需拖拉鼠标或滚动滚轮即可调整参数,可以在图像窗口实時討紙(shí)查看当前参数對(duì)最终识别效果制村,简洁、易用,实验人员可以快速上手、掌握实验菌落计数操作。
★ 无需安装驱动、无需软分城件安装,软件直接拷贝使用,兼容性强,适应不同版本的windows操作紙事系统,无需担心不同系统的软件兼容性问题。
★ 可读取平板计数、螺旋接種(zhǒng)、涂布林信法、倾注法、网格滤膜等菌落数。
★ 三级权限管理,根据登陆的权限開(kāi)放對(duì間熱)应的功能(néng),充分、有效保做車障软件的管理和应用安全(选配)。
★ 审计追踪功能(鐘通néng),设计日志模块和历史记录模块,可以随時(shí)了解仪器使用風線及更改情况,掌握仪器使用的动态情况。
★ 数据暗喝溯源功能(néng),可按需求保存检测统计结果,保存的统這雨计数据將(jiāng)自动处理些為并储存對(duì)应的培养皿菌落了南图像,为监督检测提供有效的法律依据。
★ 抗笔迹干扰功能(néng),不需要额外操作不统白睡计区域,有效避免了笔迹對(duì)识别造成(chéng)的影响。
★ 粘连菌落自动分割:Smartco個冷unter菌落智能(néng)识别技术能(néng)够自动分割粘连的菌落。制你
★ 格栅膜菌落计数:可识别网格滤膜上的菌落體又。
★ 可通過(guò)设置颜色适应、菌落比、菌落得樹直径设置,提高计数精确度。
★ 具有紅土区分8種(zhǒng)不同樣(yàng)色菌落,最大限度提高准确性; 時風;
★ 人工修正:可人工添加、删除在白菌落,對(duì)设备的统计结果進(jìn)行修正。
★ 可直接划出去除区域,方便術慢划定平皿的删除区域。


产品参数:
功能(néng) | 型号 | ||
Smartcounter-4K/A | |||
权限管理 | 三级权限 | 无 | |
光源 | 上光源 | 明暗可调 | 无 |
開(kāi)/关 | √ | ||
下光源 | 颜色可调 | 无 | |
明暗可调 | 无 | ||
開(kāi)/关 | √ | ||
模式选择 | 计数模式 | 格栅膜 | 无 |
多色统计 | 无 | ||
笔迹干扰 | 无 | ||
人工辅助识别 | √ | ||
高平整 | √ | ||
全自动模式 | 无 | ||
抑菌圈模式 | 全自动模式 | 无 | |
溯源 | 日志 | 无 | |
历史结果 | √ | ||
像素分辨率 | 829万 | ||
最小的菌落识别大小 | 0.2mm | ||
培养皿最大适用尺寸 | <150mm | ||
软件语言 | 中文/英语 | ||
主机尺寸W×D×H | 290×260×380mm | ||
工作电源 | AC100V-240V,50Hz | ||






